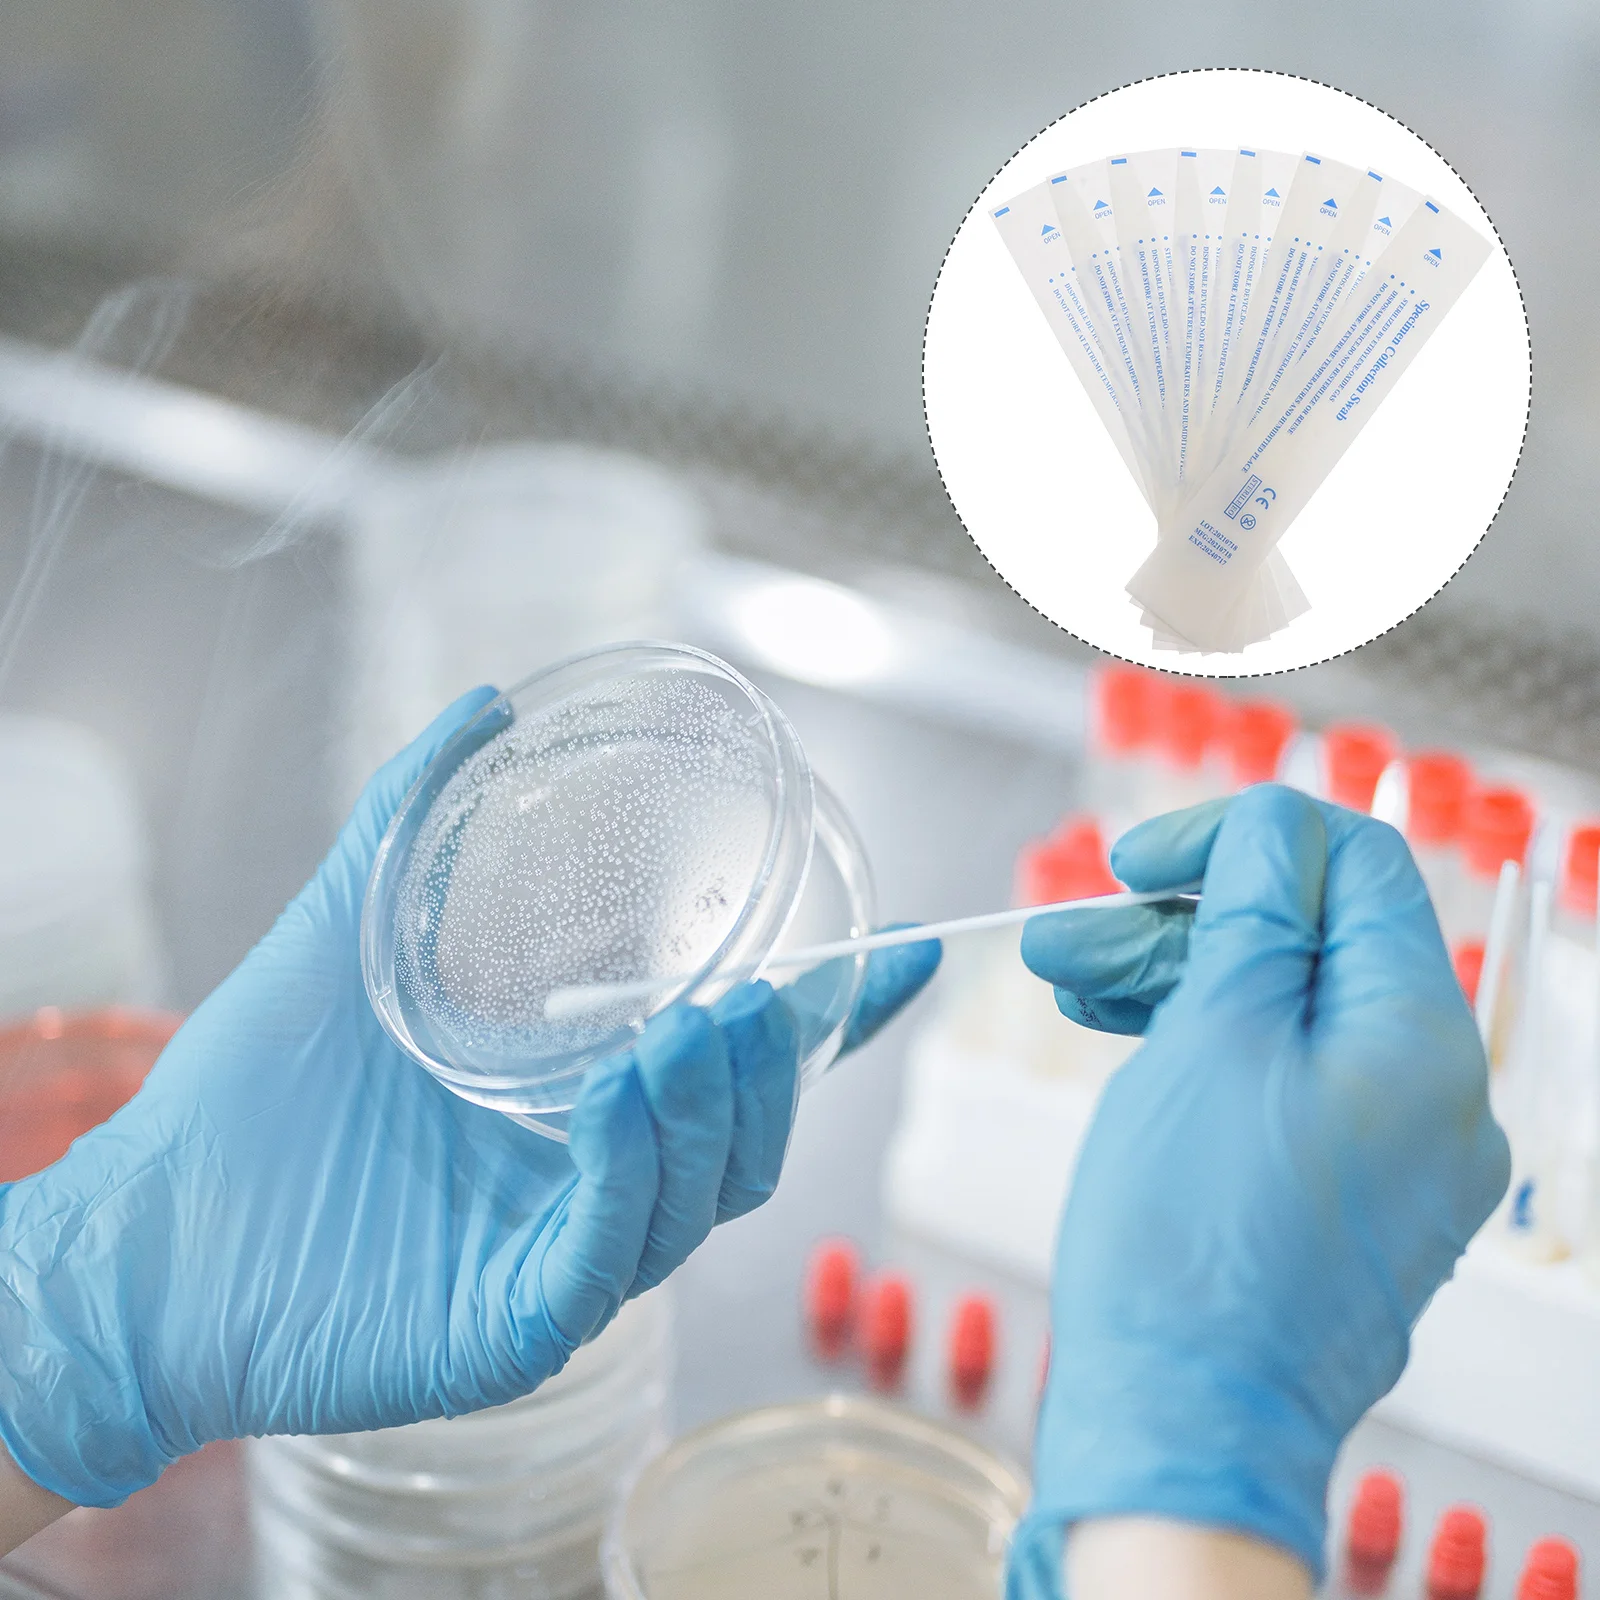
300 шт., биоразлагаемые пакеты для палочек

Защитный чехол для кровати Наматрасник Толстая стеганая простыня на подкладке Однотонное постельное белье Queen King Нескользящая простыня Пылезащитный чехол Утолщенные простыни Без наволочки Only 2 pcs Pillowcase синий
График изменения цены & курс обмена валют
Пользователи также просматривали

100.41 руб.
Type C Mobile Phone Microphone Wearable USB Lavalier Tiny Professional Degree Pickup Noise Reduction Windproof Sponge
aliexpress.com
1,665.00 руб.
Жилет для милых медведей, одежда для собак, весенне-летняя одежда для собак, одежда для кошек, одежда для собак, одежда для плюшевых мишек, одежда для толстых собак, одежда для домашних животных S
joom.ru
1,980.00 руб.
Для Polaris Для Sportsman 500 800 Для RZR Реле соленоида стартера ATV Замена реле мотоцикла Parst 4012001 4010947 CHINA
joom.ru
57,510.00 руб.
Встраиваемый в пол конвектор Varmann Ntherm N 230.110.3000 RR U EV1, Черный, Ntherm N 230.110.3000 RR U EV1
vseinstrumenti.ru
3,039.12 руб.
Комбинезоны в масштабе 1:6, джинсовый топ, юбка, комплект для куклы, женские фигурки 12 дюймов
aliexpress.ru
969.63 руб.
Cute Clouds Sky LED Light Glow Luminous Tempered Glass Phone Case For Honor V40 60 70 80 90 Pro Huawei Nova 7 8 9 10 11
aliexpress.ru
463.63 руб.
Heavy Duty Clamps For Tarps Canopy Clamps Tent Clips Camping Clips With Hooks Adjustable Fabric Clamps Canopy Clips 4 Pcs Awning
aliexpress.ru
11,075.45 руб.
Полноразмерная кровать с изголовьем кровати, с ящиками и зарядной станцией, без пружины коробки, вилка США для велосипеда, пульсометр L
aliexpress.ru
371.85 руб.
Женские платья, Клубная одежда для отдыха, костюм для танцев с цветочным принтом, с высоким разрезом, высокой талией и открытыми плечами, новая мода для женщин
aliexpress.ru
257.31 руб.
Чувствительность термометра тестер влажности для контроля температуры и влажности Прямая поставка
aliexpress.ru
62,558.48 руб.
Интеллектуальный двухмоторный стол с регулируемой высотой, компьютерный стол,
aliexpress.ru
1,729.02 руб.
Аккумулятор 750 мАч для Welch-Allyn 18200,74054,97210,20000,71000,72200,97210,11720,11730,18100,21700,74710
aliexpress.ru
884.12 руб.
Мягкие легкие флисовые одеяла в морском стиле с изображением рыбного краба, удобное теплое пушистое плюшевое одеяло из микрофибры для дивана, кровати
aliexpress.ru
2,093.81 руб.
Mini walkman player cassette tape to cd MP3 USB casstte converter, convert analog audio to MP3 WMV format through computerR
aliexpress.com
7,087.88 руб.
For Benelli BJ600GS-A Exhaust Pipe Motorcycle Delete Catalyst Mid Tube Slip On 51mm Muffler Escape Removable DB Killer 420mm
aliexpress.com
225.93 руб.
American Vintage Electric Guitar Tremolo Tension Bridge Springs for Fender Stratocaster Strat ST Nickel Plated Iron (Pack of 6)
aliexpress.com
4,000.00 руб.
Накидки Toyota Corolla Sport 2018-2023 на передние сиденья RS Алькантара, Бежевый, Toyota-112772-rs-f-beige
goods.ru
9,163.00 руб.
Литой Khw1722 (Coolray) 6,5 17 5 114,3 45 54,1 Black KHOMEN WHEELS арт. WHS520107, Черный
goods.ru
844.11 руб.
2022 розовые платья для новорожденных девочек с блестками, платья для крещения, Одежда для новорожденных, одежда для крещения, платье-пачка пр...
aliexpress.ru
942.96 руб.
Электродвигатель вентилятора с охлаждением холодильника, модель двигателя 23 Вт, охлаждающий вентилятор холодильника, детали холодильника
aliexpress.ru
2,060.86 руб.
Кеды женские парусиновые, эспадрильи с модным принтом, летние кроссовки в стиле Харадзюку, разные цвета
aliexpress.ru
14,134.97 руб.
Новые идеи по мотивам фильма, 3955 шт., подходит для 21330 домашнего домика, куклы, модель автомобиля, строительные блоки, кирпичи, детские игрушк...
aliexpress.ru
719.38 руб.
Детские сандалии для мальчиков и девочек, дышащая пляжная обувь без каблука, детские спортивные сандалии из искусственной кожи, размер Pius д...
aliexpress.ru
6,903.52 руб.
Мужская футболка с коротким рукавом BBB, новинка весны и лета, Спортивная футболка с вышивкой для молодых студентов и отдыха
aliexpress.ru
265.94 руб.
7 шт., нетканый материал, искусственная маска, Набор для творчества, маска, маска, веревка, эластичная повязка для ушей, зажимы для мостика нос...
aliexpress.ru
1,160.26 руб.
Аксессуары для конного спорта, Регулируемая Веревка на голову лошади, веревка для накидки на голову лошади для гоночных тренировок, ежеднев...
aliexpress.ru
1,674.89 руб.
ASHOWNER черное отбеливание зубов Уход за полостью рта угольный порошок натуральный активированный уголь Отбеливание зубов порошок гигиена по...
aliexpress.ru
876.28 руб.
Носки Seasame eyes для новорожденных мальчиков и девочек, повседневные зимние тапочки, нескользящие носки для младенцев, носки для детей от 0 до 24 ...
aliexpress.ru
95.71 руб.
Легко носить с собой случайный стиль Ультратонкий чехол для хранения сигарет декор для путешествий
aliexpress.com
1,254.40 руб.
plus size women swimsuit one-piece swimsuit long sleeve printing zipper woman swimsuit
aliexpress.com
1,180.66 руб.
Съемные дверные наклейки, европейская 3D стерео абстрактная серая черная Водонепроницаемая гостиная обои для двери спальни самоклеящаяся с...
aliexpress.com
341.25 руб.
Car Door Sill Stickers Edge Protector Anti Scratch Transparent Film Protection For Bmw X7 G07 Auto Accessories
aliexpress.com
1,450.52 руб.
10PCS Makeup Brushes Set Classic Fishtail Bling Cosmetic Brush For Foundation Powder Concealer
dx.com